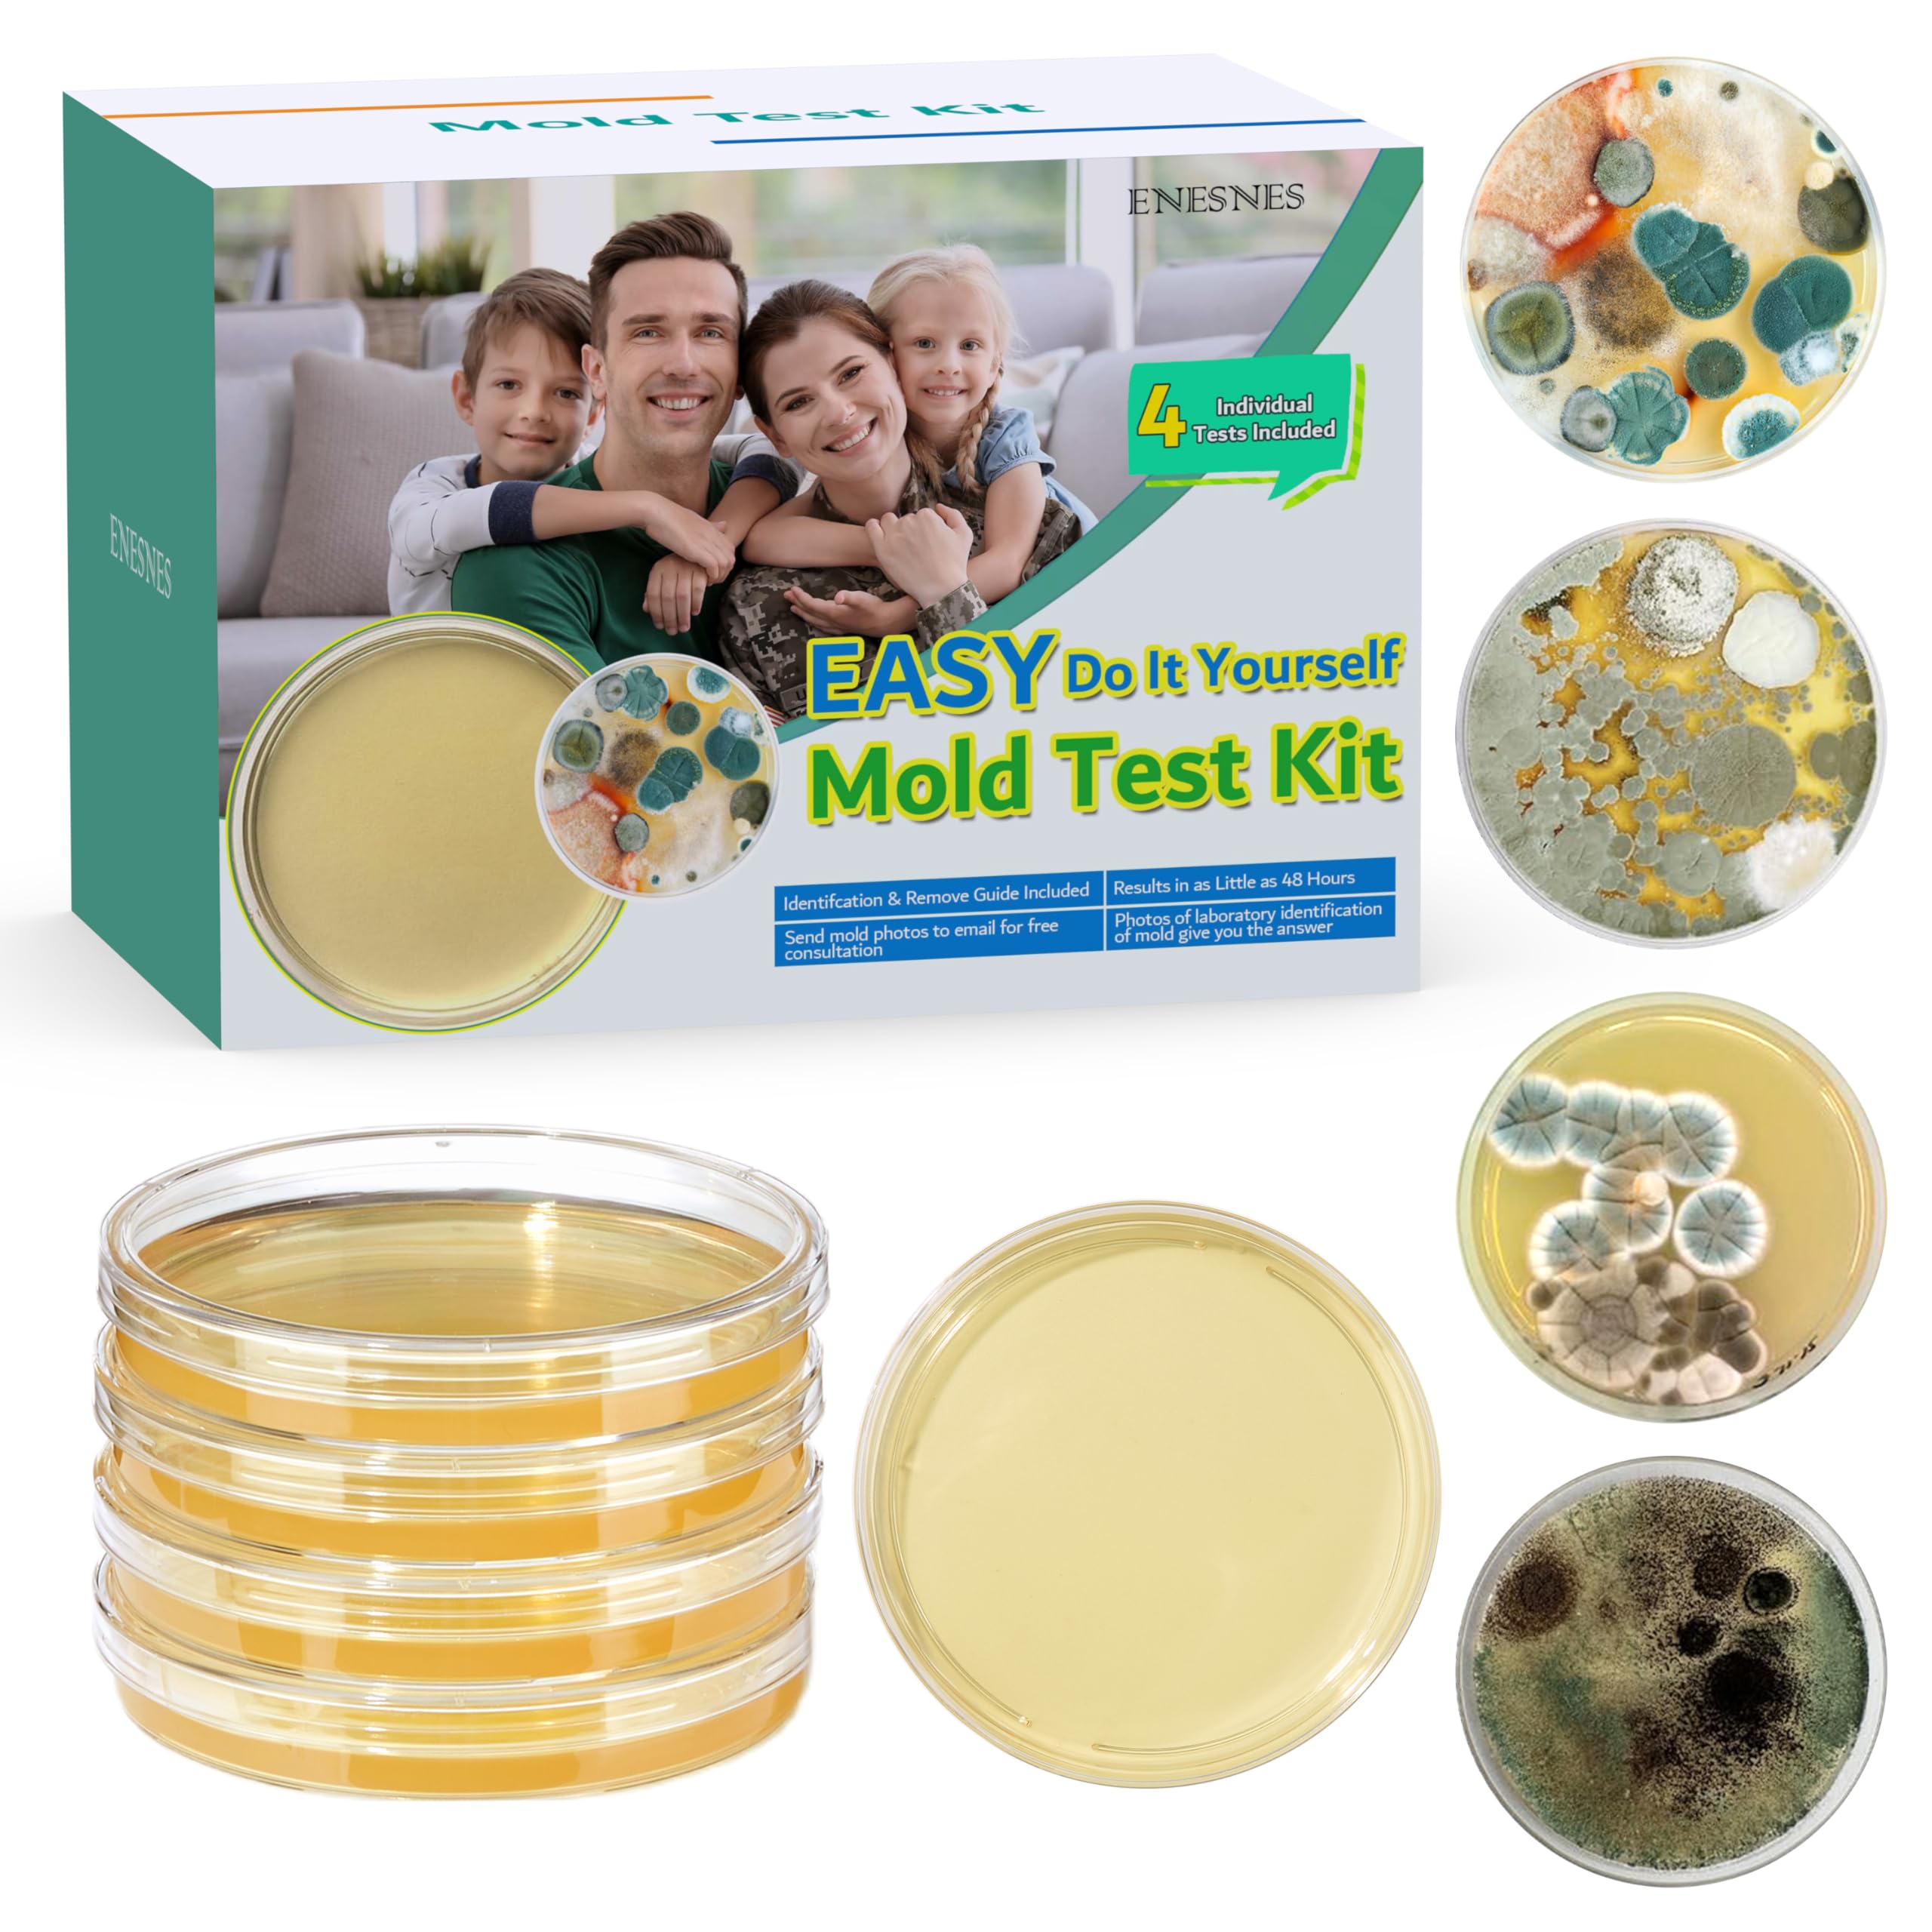
Mold Testing Kit with 4 Individual Tests - DIY Mold Test Kit for Home - Includes Detailed Mold Identification Guide - Fast and Reliable Mold Detector for Home

🏠 Detect. Identify. Defend. Your mold-free sanctuary starts here.
The ENESNES Mold Testing Kit offers 4 individual tests with 8 sterile AGAR plates, delivering fast and reliable mold detection in as little as 48 hours. Designed for versatile use on air, HVAC systems, and various home surfaces, it includes all necessary tools—swabs, gloves, labels, and a 5X magnifying glass—plus a detailed mold identification guide. Vacuum-sealed for freshness and backed by expert lab support with 24-hour photo ID service, this kit empowers you to maintain a healthy, mold-free living environment with confidence.












| ASIN | B0DPFRZMRX |
| ASIN | B0DPFRZMRX |
| Batteries Included? | No |
| Batteries Required? | No |
| Customer Reviews | 4.3 4.3 out of 5 stars (92) |
| Customer reviews | 4.3 4.3 out of 5 stars (92) |
| Date First Available | 12 January 2025 |
| Date First Available | 12 January 2025 |
| Included components | 4 Individual Tests |
| Item Package Quantity | 1 |
| Item Weight | 281 g |
| Item model number | Mold Testing Kit-010 |
| Item model number | Mold Testing Kit-010 |
| Manufacturer | ENESNES |
| Manufacturer | ENESNES |
| Part number | Mold Testing Kit-01 |
| Power source type | No need |
| Product Dimensions | 8.89 x 8.89 x 1.52 cm; 281.23 g |
| Product Dimensions | 8.89 x 8.89 x 1.52 cm; 281.23 g |
A**R
Great and easy to use
S**.
Genial, alles ist supersauber verpackt, mit sterilen Tupfern und Handschuhen, toller Anleitung und die „Nachsorge“, die die gezüchteten Schimmel bestimmt (email mit Foto einsenden und auf Antwort warten). Das ist das Allerbeste. So kann ich nach deren Anleitung den Schimmel spezifisch bekämpfen. Wie steht in der Anleitung. Mina hat die Bestimmung zeitnah und sehr engagiert durchgeführt. Lieben Dank dafür. Hoffentlich nie wieder- aber wenn, dann nur mit Euch. Sehr empfehlenswert.
F**O
I purchased this mold test kit to check some suspicious spots in my home, and I'm blown away by how well-designed and effective it is! Let me break it down: First of all, the kit arrived in super secure packaging—everything was neatly organized, and the petri dishes were vacuum-sealed to keep them sterile. It felt professional and trustworthy right out of the box. Secondly, I tested multiple areas—my basement (which always smells damp), bathroom corners, bedroom windowsills, and even the stairwell. The instructions were crystal clear, and within 2 days, I had visible growth in the petri dishes. The results were eye-opening and matched the musty spots I suspected. Thirdly, Here's the kicker—the free mold analysis report from the seller was a game-changer! I send my samples to them, and within 12 hours, they sent back a detailed report identifying the mold types and even tips on how to handle them. No vague answers—just straight-up helpful info. The point that touched me the most, My 8-year-old daughter hijacked the included magnifying glass and now uses it to inspect EVERYTHING—bugs, leaves, even her snacks. It’s such a fun, unexpected add-on that turned into a mini science adventure for her. Genius touch! Final Thoughts: This kit is a 10/10 for anyone worried about mold. The seller clearly put thought into every detail—from the airtight packaging to the lightning-fast expert support. No cons here, just a reliable, user-friendly product backed by awesome customer care. Highly recommend for peace of mind! Pros: -Professional, vacuum-sealed packaging. -Easy to use with accurate results. -FREE expert analysis (super fast!). -Kid-friendly magnifying glass bonus. -Outstanding customer service. If you're on the fence about testing for mold, grab this kit. It's thorough, affordable, and the after-sales support is top-notch. Five stars all the way!
L**.
I took samples as soon as it came and placed in my 3D printer bed to incubate. I found nothing serious growing in my HVAC which is good news to me. Great product for a quick home check.
A**E
I bought this to test for mold in a new building I was working in. I got terribly sick and suspected mold. I was shocked to say the least at the results I got. I couldn't really tell what the mold was, so I sent an email in the late afternoon to the company and got a reply within 12 hours. They identified everything and gave information for me. I tested again in 3 months after cleaning the room and running an air purifier. I again sent the results to the email and just as quickly got my answers.
Trustpilot
2 days ago
1 month ago